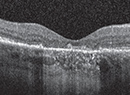

June 2015
Features

10 Abstracts Worth a Second Look
A review of compelling presentations in retina from ARVO.

An Update on the Intravitreal Injection Procedure
Using recent ‘guidelines’ and best practices to optimize outcomes.
Dry AMD Progression in Wet AMD
What we know and don’t know about geographic atrophy.

Genetic Testing for Age-Related Macular Degeneration
With great promise come many controversies and questions.
Departments
Clinical Trial Closeup
Impact of the OHR-102 IMPACT Data
A closer look at combination therapy and CNV.
Coding Commentary
Genetic Tests: A Coverage Challenge
AAO advises restraint with genetic testing; payers go slow.
Editor's Page
Innovation Insight
Experience of 50 Vitrectomies with EVA
Smooth transition between vacuum and flow modes.
Medical Retina Fellows Forum
The Controversy of Band #2
What should we call the second of four outer retinal hyperreflective bands on OCT imaging?
News
Retina CEO
How to Supercharge Billing Functions
How quantitative accountability can improve cash flow.
Retina Rounds
A Case of Blurry Vision and Photopsias
Could a history of uveitis have a role in acute, unilateral worsening vision over three days?



